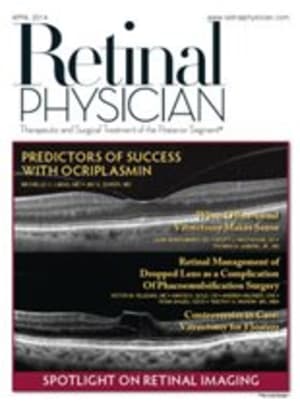
Retinal Physician

Articles
Coding
By Suzanne L. Corcoran, COE
Imaging the Evolution of Dry AMD
Advancements in imaging have resulted in greater ability to diagnose and perhaps treat dry AMD.
Predictors of Success With Ocriplasmin in VMT and FTMH
In cases of vitreomacular traction and macular hole, choice of treatment can make a big difference.
Retinal Management of Dropped Lens As a Complication Of Phacoemulsi cation
Tips for the posterior-segment surgeon
Spectral-domain OCT of the RPE
Optical coherence tomography has evolved to the extent that we can now image the retinal microstructure.
Subspecialty News
Company targets both wet and dry AMD.
When Office-based Vitrectomy Makes Sense
The authors share their experience performing vitreoretinal surgery in the office.
Widefield OCT: Current and Future Applications
When retinal pathology goes beyond the macula, imaging can pose a challenge.
Dexamethasone Intravitreal Implant Following RVO: Rescue, Adjunct or Primary Therapy?
Ozurdex can be a safe, effective treatment option for macular edema in all three scenarios.
By Desiree Ifft, Contributing
Diagnosis and Monitoring of RVO and Secondary Macular Edema
Advances in technology, such as ultra-widefield angiography and spectral domain OCT, aid in patient management.
By Theodore Leng, MD, FACS
Macular Laser in the RVO Treatment Paradigm
This treatment option remains useful in many situations and is being examined anew as part of combination therapy.
By Seenu M. Hariprasad, MD
MicroPulse™ Laser Therapy as an Effective, First-Line Treatment for Juxtafoveal Telangiectasia
Case Report: MicroPulseTM Laser Therapy
Reframing How We Think About Treatment for RVO
Changing therapy options require a change in our approach.
By Pravin U. Dugel, MD